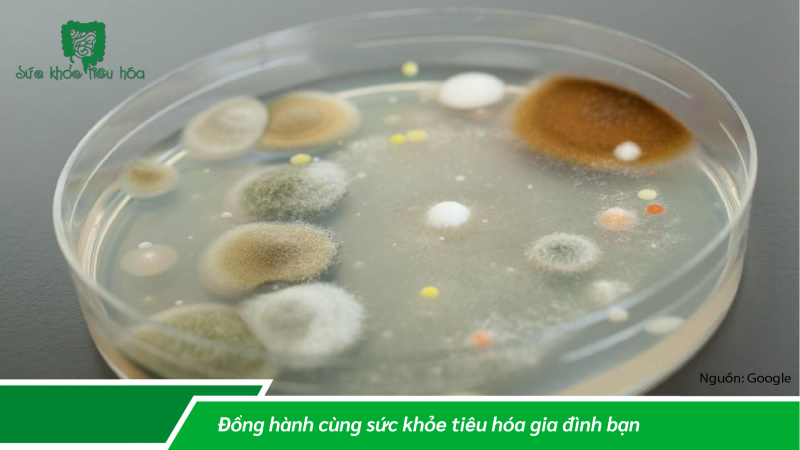
GÓC NHÌN MỚI VỀ HỆ VI SINH & SỰ LÊN MEN TRONG NĂM 2022

GÓC NHÌN MỚI VỀ HỆ VI SINH & SỰ LÊN MEN TRONG NĂM 2022
Ngày 19/10/2022
Vi khuẩn ở khắp mọi nơi trong cuộc sống của chúng ta. Chúng ta đã học cách chống nó trong một thời gian dài, trước khi thay đổi quan điểm của mình về nó một chút. Thực tế, vi khuẩn có thể có lợi. Sự quan tâm ngày càng tăng đối với hệ vi sinh vật và các sản phẩm lên men là một trong những dấu hiệu cho thấy phát triển quan điểm của chúng ta về những vi sinh vật mà loài người luôn sống chung từ lâu.
Những tiến bộ của y học đã khiến chúng ta nhận thức được sự nguy hiểm của vi khuẩn có thể gây đau thắt ngực, viêm dạ dày ruột hoặc bệnh tả. Nhưng không phải tất cả đều gây bệnh, và một số thậm chí có thể có lợi.
HỆ SINH THÁI VI SINH VẬT
Có một nghìn tỷ loài vi sinh vật trong khi chỉ có mười triệu loài động vật. Chúng hoàn toàn ở khắp mọi nơi: trên không, dưới đất, dưới nước. Theo tạp chí Socialter, những sinh vật đơn bào này có kích thước từ 1 đến 10 micromet “điều chỉnh hệ sinh thái, điều chỉnh dòng chảy cacbon và nitơ, tạo ra một nửa lượng ôxy sẵn có, hình thành cộng sinh với tất cả các sinh vật sống, bảo vệ chống lại vi khuẩn gây bệnh, tạo điều kiện hấp thụ chất dinh dưỡng, hướng dẫn hệ thống miễn dịch và điều chỉnh các thông số sinh lý... ”
Và từ một thời gian qua, vi khuẩn đã được nuôi cấy để đáp ứng các nhu cầu mới và thậm chí giúp chúng ta giảm thiểu tác động của môi trường.

HỆ VI SINH VẬT VÀ SỰ LÊN MEN
Sự phục hồi đã bắt đầu với hệ vi sinh vật. Đột nhiên, chúng ta cảm thấy hứng thú khi quan tâm đến đời sống bên trong ruột của chúng ta và những vi sinh vật này nếu không có chúng, chúng ta sẽ bị chướng bụng, đầy hơi hoặc quá trình tiêu hóa bị xáo trộn nghiêm trọng. Vi khuẩn là cơ sở của nguyên tắc lên men, đã mang lại sức sống mới cho các loại thực phẩm như sữa chua, dưa chua hoặc dưa cải muối.

Trong quá trình lên men, vi sinh vật tiêu thụ đường và nước có trong thực phẩm. Bằng cách nhân lên, những sinh vật siêu nhỏ này sẽ thay đổi mùi vị cũng như kết cấu và thậm chí cả màu sắc của thực phẩm. Chúng cũng có thể làm tăng hàm lượng vitamin B và C, cũng như kẽm và sắt trong thực phẩm và thậm chí làm cho protein dễ tiêu hóa hơn.
Mùa hè năm ngoái, các nhà nghiên cứu Mỹ từ Trường Y Stanford đã phát hiện ra rằng chế độ ăn uống giàu thực phẩm lên men trong mười tuần làm tăng sự đa dạng của hệ vi sinh vật và thậm chí có thể duy trì cân nặng, giảm nguy cơ mắc bệnh tiểu đường, ung thư cũng như bệnh tim mạch. Nên ăn sáu loại thực phẩm như vậy để trải nghiệm những tác dụng có lợi. Trên thực tế, vi khuẩn rất cần thiết cho chế độ ăn uống của chúng ta vì các sản phẩm lên men chiếm từ 5 đến 40% chế độ ăn uống của con người, tùy thuộc vào văn hóa ẩm thực.
Năm năm trước, một nghiên cứu của BIS Research ước tính rằng thị trường nguyên liệu lên men sẽ trị giá 888,76 tỷ USD vào năm 2023.
Các nhà sản xuất đã làm việc trong vài năm qua để cải tiến thực phẩm có vi khuẩn "tốt". Lấy ví dụ về nước ép dưa chua được phát triển đặc biệt cho các vận động viên bởi Công ty Nước ép dưa chua thương hiệu của Mỹ, mà họ đã trình bày tại hội chợ đổi mới thực phẩm quốc tế ở Paris vào năm 2018. Về phần mình, thương hiệu Hàn Quốc Ligaro đã biến tấu món kim chi của mình - một biểu tượng K- chế biến món ăn dựa trên bắp cải và ớt, cả trong... mứt!
VI KHUẨN TRONG MỸ PHẨM?
Nhưng vi trùng không chỉ có trong đĩa thức ăn. Chúng cũng thấm vào kem chống nhăn, serum dưỡng ẩm và các sản phẩm khác của chăm sóc sắc đẹp . Các thương hiệu mỹ phẩm đã thực sự nhận ra rằng quá trình lên men cũng có thể hữu ích cho họ: bằng cách để những sinh vật siêu nhỏ này sinh sôi nảy nở, chúng ta sẽ thu được nồng độ chất dinh dưỡng và chất chống oxy hóa tốt hơn. Trên thực tế, các thành phần hoạt tính sẽ được thúc đẩy bởi quá trình lên men. Trong một báo cáo gần đây, công ty phân tích và hướng dẫn tiêu dùng Mỹ WGSN do đó nghiễm nhiên đặt cược vào việc làm đẹp lên men như một xu hướng sẽ bùng nổ vào năm 2022.
ĐỔI MỚI CÔNG NGHỆ SINH HỌC…

Vi khuẩn là một trong những vật trung gian chính cho sự phát triển của công nghệ sinh học và vô số ứng dụng của chúng. Gần đây, các nhà nghiên cứu tại Viện Nghiên cứu Khoa học Quốc gia (INRS) ở Quebec đã nghiên cứu các phân tử được tạo ra bởi vi khuẩn có khả năng tiêu diệt... vi khuẩn khác. Một khám phá mới nhằm tạo ra một loại xà phòng trong tương lai, có khả năng thay thế chất tẩy rửa hiện tại hoặc gel chứa cồn hydro...
Vi khuẩn vẫn có thể giúp chuyển đổi khí nhà kính biến đổi khí hậu thành chai dầu gội đầu hoặc ethanol cho nước hoa, hoặc thậm chí là kính đeo mắt, túi xách và các loại túi sang trọng khác cho điện thoại thông minh và máy tính xách tay.
AustrapharmVN
Nguồn tham khảo: MICROBIOME, FERMENTATION : EN 2022, UN NOUVEAU REGARD SUR LES BACTÉRIES ! 28 - 01- 2022
https://www.premiumbeautynews.com/fr/microbiome-fermentation-en-2022-un,19778
Bài viết liên quan
